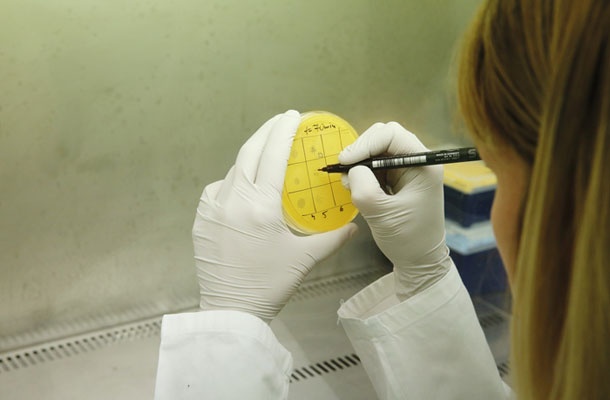

Zdravje / Teror bakterij
Mikroskopska grožnja svetovnih razsežnosti
Staš Zgonik
MLADINA, št. 22, 3. 6. 2016

Analiza infektivnosti bakteriofagov v laboratoriju podjetja AmpliPhi v Ljubljani
© Borut Krajnc
Konec prejšnjega tedna je udarila novica, da so v ZDA odkrili bakterijo, odporno proti kolistinu, antibiotiku, ki ga v medicini uporabljajo kot antibiotik najvišjega reda, kot zadnjo obrambo pred okužbo, ko drugi antibiotiki niso učinkoviti. Odkrili so jo pri 49-letni ženski, ki so jo zdravili zaradi okužbe sečil. Čeprav so slovenski mediji večinoma pisali, da gre za odkritje bakterije, odporne proti vsem znanim antibiotikom, to ne drži. Je pa odkritje še vedno skrb zbujajoče. Kaže namreč na to, da je bakterijski gen, ki bakterijam omogoča odpornost proti kolistinu, že razširjen po tako rekoč vseh delih sveta in da je samo vprašanje časa, kdaj se bo znašel v kakšni od bakterij, odporni proti vsem ostalim znanim antibiotikom.
Staš Zgonik
MLADINA, št. 22, 3. 6. 2016
Analiza infektivnosti bakteriofagov v laboratoriju podjetja AmpliPhi v Ljubljani
© Borut Krajnc
Konec prejšnjega tedna je udarila novica, da so v ZDA odkrili bakterijo, odporno proti kolistinu, antibiotiku, ki ga v medicini uporabljajo kot antibiotik najvišjega reda, kot zadnjo obrambo pred okužbo, ko drugi antibiotiki niso učinkoviti. Odkrili so jo pri 49-letni ženski, ki so jo zdravili zaradi okužbe sečil. Čeprav so slovenski mediji večinoma pisali, da gre za odkritje bakterije, odporne proti vsem znanim antibiotikom, to ne drži. Je pa odkritje še vedno skrb zbujajoče. Kaže namreč na to, da je bakterijski gen, ki bakterijam omogoča odpornost proti kolistinu, že razširjen po tako rekoč vseh delih sveta in da je samo vprašanje časa, kdaj se bo znašel v kakšni od bakterij, odporni proti vsem ostalim znanim antibiotikom.
O odkritju gena za odpornost proti kolistinu so novembra lani prvi poročali kitajski znanstveniki, njihova objava pa je sprožila mrzlično iskanje gena tudi v zahodnem svetu. In že marca letos so nizozemski znanstveniki sporočili, da so gen odkrili v nekaj vzorcih piščančjega mesa, ki so ga kupili v tamkajšnjih supermarketih.
»Kolistin je zelo star antibiotik, ki se dolgo časa ni uporabljal, ker zaradi učinkovitosti ostalih ni bilo potrebe, ob tem pa je veljal tudi za manj učinkovitega in toksičnega,« pravi dr. Bojana Beovič z ljubljanske Infekcijske klinike. »Danes se vedno več uporablja, ker je še edini antibiotik, ki je učinkovit proti nekaterim bakterijam. Še pred desetimi leti ga sploh nismo uporabljali. Danes ga predpisujemo praktično vsak dan.«
Ker je kolistin zadnje zatočišče za zdravljenje okužb pri ljudeh, je praktično norost, da se na veliko uporablja v veterinarski medicini, predvsem za zdravljenje črevesnih okužb pri prašičih. Za uporabo pri živalih kolistin izdeluje celo Krka.
Globalno pešanje
Povečevanje odpornosti bakterij proti antibiotikom je težava, stara skoraj toliko kot antibiotiki sami. Prvo bakterijo, odporno proti penicilinu, so odkrili le štiri leta po začetku njegove množične uporabe med drugo svetovno vojno. V letih po tem se je nabor antibiotikov naglo širil in bakterije, četudi so pridobivale nove in nove obrambne sposobnosti, niso dohajale tempa. V zadnjih desetletjih so se vloge zamenjale. Razvoj novih antibiotikov se je ustavil. In danes farmacija ne sledi več hitrosti, s katero bakterije razvijajo nove in nove odpornosti proti antibiotikom.
Gre za globalni problem, ki je v svojem bistvu zelo podoben podnebnim spremembam. Podnebne spremembe povzroča prekomerna poraba fosilnih goriv, zaradi katere se v ozračju kopičijo toplogredni plini, bakterijske spremembe povzroča prekomerna raba antibiotikov, ki bakterije izpostavlja selekcijskemu pritisku. Zelo podobna sta si problema tudi v tem, da se o njih govori že zelo dolgo, ukrepi pa so še vedno precej blagi, saj gre za težavo, ki nas v vseh svojih razsežnosti čaka šele v prihodnjih desetletjih, za njeno rešitev pa bo potreben globalen dogovor.
Na svetu že danes zaradi odpornosti bakterij proti antibiotikom umre približno 700 tisoč ljudi na leto. »Že tako velika številka se bo brez ukrepanja do leta 2050 dvignila na 10 milijonov smrti na leto, kar je več od števila ljudi, ki na leto umrejo zaradi raka,« je v nedavno objavljenem poročilu o grožnji odpornih bakterij, ki jo je naročila britanska vlada, zapisal ekonomist Jim O’Neill. En človek vsake tri sekunde.
V razvitem svetu zaradi odpornih bakterij danes večinoma umirajo bolniki, ki so že tako v zelo slabem stanju in se njihovo telo ni sposobno učinkovito boriti proti okužbi. A z nadaljnjim razvojem odpornosti bodo ogrožene tudi rutinske operacije, vključno z na primer carskimi rezi, pri katerih za preprečitev okužbe uporabljajo antibiotike. Ogroženi bodo tudi onkološki bolniki, katerih imunski sistem je zaradi kemoterapije oslabljen. Skratka, zaradi odpornosti bakterij proti antibiotikom bodo vse pogosteje umirali bolniki, ki bi si sicer lahko obetali še dolgo življenje.
S povečevanjem bakterijske odpornosti bodo ogrožene povsem rutinske operacije, na primer carski rezi, pri katerih za preprečitev okužb uporabljajo antibiotike.
V Sloveniji problem odpornih bakterij za zdaj še kolikor toliko obvladujemo, se pa stanje nenehno slabša. »Narašča na primer odpornost pri bakteriji E. coli, ki je zelo pogost povzročitelj okužb, tudi takih, ki nastanejo zunaj bolnišnic. Vse več je bolnikov, ki imajo na primer okužbo sečil, pri katerih običajni antibiotiki ne pomagajo več in jih morajo pri nas zdraviti z intravenoznimi antibiotiki,« opaža Bojana Beovič. Primere najtrdovratnejših okužb za zdaj večinoma dobivajo iz tujine, ko se ljudje okužijo med potovanjem.
Kapitalni problem
Obstaja kopica možnosti za ukrepanje. Problem pa sta volja in denar. Farmacevtska podjetja nimajo finančne spodbude za razvoj novih vrst antibiotikov, ki bi jih zdravniki nato uporabljali zgolj v skrajni sili. V tem pač ni dobička. Pa tudi ob množični uporabi so antibiotiki, ki jih ob okužbi praviloma jemljemo teden ali dva, manj dobičkonosni od zdravil za kronične bolezni, ki jih je v številnih primerih treba jemati neprekinjeno do konca življenja. Novi antibiotiki, ki občasno vseeno pridejo na tržišče, praviloma uporabijo le nove variacije že znanih mehanizmov delovanja, zaradi česar se bakterije lahko hitro prilagodijo nanje. Raziskave, potrebne za odkritje povsem novega mehanizma, zaradi visokih stroškov niso rentabilne.
Problema se zavedajo tudi farmacevtska podjetja, ki so na letošnjem svetovnem ekonomskem forumu v Davosu predstavila svoj poziv vladam, naj jim zagotovijo primerne finančne spodbude za razvoj novih antibiotikov. Ker prosti trg v tem primeru pač ne deluje.
Najabsurdnejše je dejstvo, da tako rekoč nobena država nima na voljo niti vseh obstoječih antibiotikov. Ker pač proizvajalci zaradi slabega povpraševanja ne obnavljajo zalog. In Slovenija kot zelo majhno tržišče ima s tem seveda velik problem. »Ves čas,« pravi Bojana Beovič. »Nekaterih antibiotikov sploh nimamo, drugi pridejo in izginejo. S tem se ukvarja ves razviti svet. Italijani na primer sploh nimajo navadnega penicilina v obliki tablet in namesto tega uporabljajo bolj širokospektralne antibiotike, ki imajo večji vpliv na odpornost. Pri nas nimamo predvsem nekaterih zdravil za zdravljenje vnetja sečnega mehurja.«
Enako pomembno v boju proti odpornosti bakterij je zmanjševanje porabe antibiotikov, ki jih je v številnih državah mogoče dobiti tudi brez zdravniškega recepta, hkrati pa jih tudi zdravniki sami pogosto preveč radodarno predpisujejo.
Slovenija glede predpisovanja antibiotikov negativno odstopa predvsem na področju pediatrije. V povprečju vsakemu otroku v predšolskem obdobju enkrat na leto predpišejo antibiotik, pa čeprav gre še vedno prepogosto za okužbe dihal, ki so virusne, zaradi česar antibiotik nima prav nikakršnega učinka. »K temu pripomorejo tudi starši, ki si zaradi socialne ogroženosti ne morejo privoščiti odhoda na bolniško in od zdravnika pričakujejo instantno rešitev,« pravi Bojana Beovič.
Pri odraslih je stanje boljše. V povprečju na tisoč prebivalcev vsak dan antibiotike, ki jim jih je predpisal osebni zdravnik, prejema 15 ljudi, s čimer smo med najboljšimi v Evropski uniji. »Je pa to še vedno približno enkrat več, kot bi bilo potrebno.«
Alternativci
Samo novi antibiotiki ne bodo dovolj. V boju proti odpornosti bakterij bo treba uporabiti tudi alternativne možnosti. Eno pomembnejših je cepljenje proti bakterijskim okužbam. Če namreč okužbo preprečimo s cepljenjem, je ni treba zdraviti z antibiotiki, s čimer zmanjšamo njihovo porabo in bakterij ne izpostavimo selekcijskemu pritisku. Cepljenje proti okužbi s pnevmokoki je na primer v Sloveniji otrokom na voljo brezplačno. Ni pa obvezno, zaradi česar je precepljenost za zdaj slaba. »V državah, v katerih je bolj razširjeno, ima cepljenje proti pnevmokokom zaznaven ugoden vpliv na zmanjšanje antimikrobne rezistence,« je jasna Bojana Beovič.
Druga alternativa na dosegu roke pa so bakteriofagi, naravni sovražniki bakterij. Gre za viruse, ki napadajo izključno bakterije, ljudem pa so nenevarni. V naših telesih jih gostuje na milijarde. Pravzaprav so bakteriofagi najbolj množična oblika življenja na svetu, saj njihovo število nekajkrat presega število bakterij.
Problem sta volja in denar. Farmacevtska podjetja nimajo finančne spodbude za razvoj novih vrst antibiotikov, ki bi jih zdravniki nato uporabljali zgolj v skrajni sili.
Problem sta volja in denar. Farmacevtska podjetja nimajo finančne spodbude za razvoj novih vrst antibiotikov, ki bi jih zdravniki nato uporabljali zgolj v skrajni sili.
Bakteriofage so kot zdravilo proti bakterijskim okužbam poznali že pred antibiotiki. Prav prihod antibiotikov pa jih je odrinil v senco. Njihova uporaba se je zaradi pomanjkanja antibiotikov ohranila le v nekdanjem komunističnem bloku pod vplivom Sovjetske zveze. Zato pa se danes številni bolniki iz zahodne Evrope zaradi pomanjkanja učinkovitih antibiotikov zgrinjajo v gruzijsko prestolnico Tbilisi, saj tamkajšnji Inštitut Eliava velja za središče znanja o bakteriofagnem zdravljenju trdovratnih okužb.
Po mnenju Bojane Beovič bi bili bakteriofagi zelo dobrodošlo orožje v boju proti bakterijam, a na tem področju se stvari že dolgo časa niso premaknile. »Princip delovanja je zanimiv in je učinkovit, problem pa je v standardizaciji pripravkov, ki je potrebna za široko uporabo.«
V zahodnem svetu trenutno potekata najmanj dve klinični raziskavi bakteriofagnih pripravkov. In Slovenija ima pri tem pomembno vlogo.
V pritličju modre poslovne stavbe v Dobrunjah pri Ljubljani so prostori ameriškega podjetja AmpliPhi. Pod vodstvom njihovega direktorja za razvoj procesov in proizvodnje dr. Frenka Smrekarja tam poteka gojenje bakteriofagov, izoliranih iz okolja, ki napadajo bakterijo Staphilococcus aureus. »Ravno minuli teden smo začeli raziskavo prve klinične faze v ZDA v sodelovanju z ameriško vojsko.« V začetku letošnjega leta so podobno raziskavo začeli tudi v Avstraliji.
Velika farmacevtska podjetja za zdaj zgolj opazujejo razvoj. »Ko bo prvi bakteriofagni produkt uspešno prestal vse klinične faze oziroma vsaj začetne faze, bo zanimanje za nadaljnji razvoj brez dvoma naraslo.«
Celotno podjetje AmpliPhi ima 25 zaposlenih. 14 jih dela v Sloveniji. Kljub temu pa utegne za posamezne bolnike kmalu postati pomembnejše od Krke in Leka skupaj.